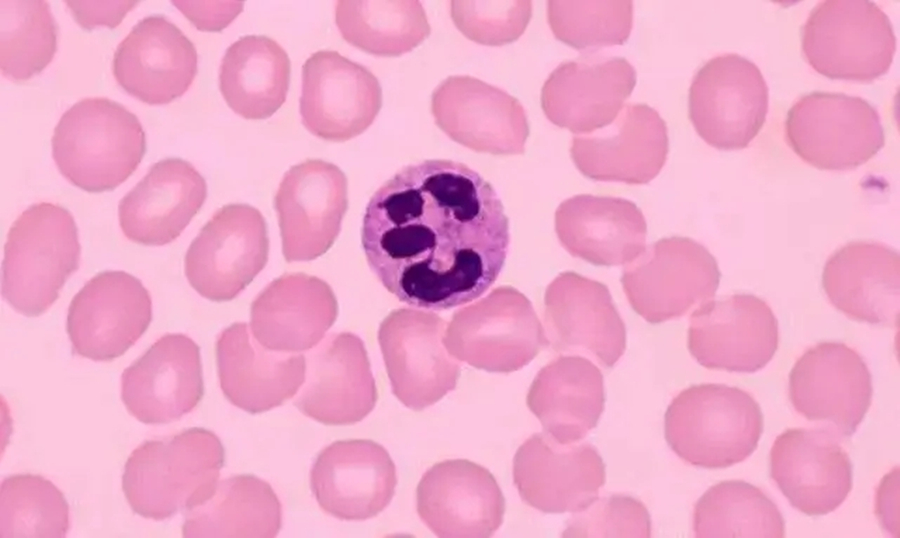

揭密TBM的起源和行為之謎_風聞
根新未来-03-21 10:35
文/陳根
人類的自身免疫性疾病是一類免疫系統攻擊身體的疾病,其中包括類風濕性關節炎、紅斑狼瘡和多發性硬化症等多種疾病,影響了全球的大量患者。那麼,這些疾病的確切原因是什麼,又該如何防治呢?
自身免疫疾病的由來與防治
在人體免疫反應發生時,包括脾、淋巴結、咽扁桃體、闌尾,以及分佈全身的淋巴小結和淋巴組織等次級淋巴器官中,會形成一些瞬態的特殊區域——生髮中心(germinal centers,GC)。在生髮中心,被抗原激活的B細胞將經歷一個名為“親和力成熟”的過程,使得其所產生的抗體親和力逐漸提高。在“優勝劣汰”生存法則的作用下,將產生大量的“被淘汰者”。據估計,生髮中心每5.3小時就有半數的B細胞死亡。然而,在死亡的過程中,隨之產生的細胞質和細胞核碎片很可能會引發自身免疫反應,因此,清理這些“屍體”的機制能否正常運作至關重要。
如果沒有及時清理,死亡細胞的內容物就會引發自身免疫性疾病的發生。而可染體巨噬細胞,即TBM(tingible body macrophages),是淋巴結中一種特殊的巨噬細胞,可以清除免疫系統自身產生的廢物,包括死亡的細胞和蛋白質等。在清除這些廢物的過程中,它們將助力於人體防止自身免疫性疾病的發生。

破解TBM的起源之謎
在過去140年的發展過程中,TBM的起源和行為一直是一個謎。直到日前,澳大利亞加文醫學研究所的科學家們在新一代雙光子顯微鏡的助力下,才首次追蹤了TBM的生命週期和功能,並進入活體動物的淋巴結內的微觀結構,實時觀察細胞活動。
據研究表明:使用紅色熒光蛋白tdTomato(TOM)不可逆標記表達CD169的細胞及其後代,發現在尚未形成生髮中心的濾泡內,TOM+巨噬細胞具有樹突狀突起。免疫接種後,則在形成的生髮中心中,出現了更大、更圓、更多空泡化的TOM+巨噬細胞。細胞中含有凋亡小體證實其確為TBM。而使用Kikume Green-Red(KikGR)熒光蛋白追蹤TBM的來源發現,與組織駐留的SSM細胞類似,98%的TBM發生了光轉換,即表明其大部分為組織駐留。組織駐留的巨噬細胞其發育通常依賴於CSF1R信號,然而阻斷CSF1R信號並未影響TBM的產生,即TBM源自CSF1R 阻斷抗性淋巴結駐留巨噬細胞。

TBM的“懶惰”捕食法
TBM對死亡細胞的清理,並非勤勞地遊走尋獵,而是伸出許多的細胞突起來“打撈”遊移的凋亡細胞碎片。對該動力學過程進行數學建模表明,細胞突起使得TBM能夠掃描大約細胞體6倍大小的體積,且當TBM體積較大時,或生髮中心中凋亡細胞碎片的密度較高時,這種“捕獵”策略將優於“追逐獵物”的策略。
目前,人們對TBM的研究,還侷限於TBM在健康動物模型中的行為。未來,將進一步拓展到自身免疫模型,以嘗試找出挽救崩潰的免疫系統並從根本上提升自身免疫疾病的方法。